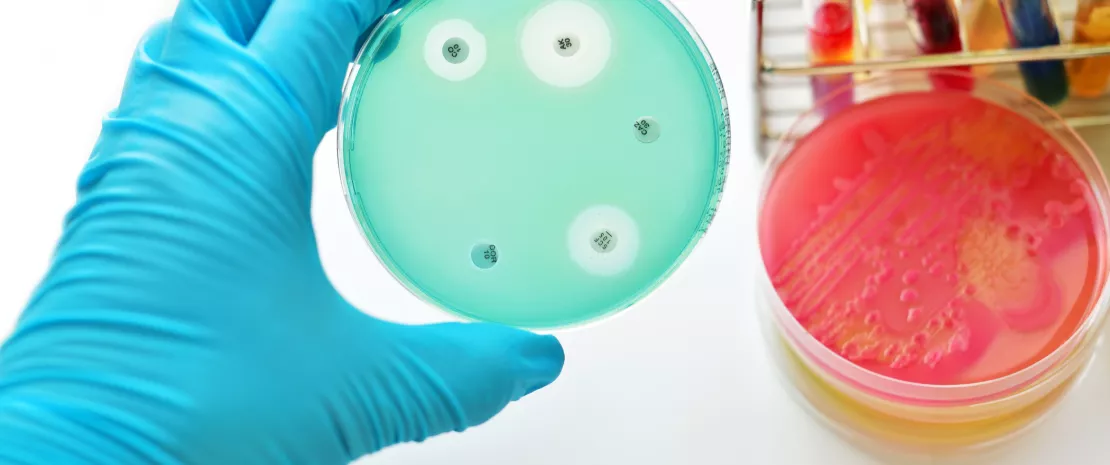
Actu PRO : La transplantation fécale, solution à l’antibiorésistance chez les patients immunodéprimés ?

La transplantation fécale, solution à l’antibiorésistance chez les patients immunodéprimés ?
Pour lutter contre les infections à bactéries multi-résistantes, la transplantation de microbiote fécal confirme non seulement son efficacité mais également sa sûreté, y compris chez des patients immunodéprimés, révèle une étude franco-italienne.
en_sources_title
en_sources_text_start en_sources_text_end
A propos de cet article
« L’une des plus graves menaces pesant sur la santé mondiale, la sécurité alimentaire et le développement. »
C’est en ces termes que l’OMS parle aujourd’hui de la résistance aux antibiotiques, qui entraîne une prolongation des hospitalisations, une augmentation des dépenses médicales et une hausse de la mortalité. Au rang des solutions investiguées, la transplantation de microbiote fécal (TMF) est porteuse d’espoir pour éradiquer les bactéries multi-résistantes mais soulève encore des interrogations concernant sa sécurité, notamment chez les patients immunodéprimés.
10 patients immunodéprimés testés
Une étude monocentrique a reposé sur l’analyse rétrospective de 10 patients atteints d’hémopathie, en cours de greffe de moelle osseuse et colonisés (ou l’ayant été) par des bactéries productrices de carbapénèmases ou résistantes à la vancomycine et à très haut risque (classées eXDR, pour emerging extensively drug-resistant bacteria). Ceux-ci devaient bénéficier d’une allogreffe (donneur différent du receveur) de cellules souches hématopoïétiques (CSH) suite au traitement de leur tumeur hématologique. La TMF a été réalisée par lavement majoritairement ou sonde naso-gastrique ; elle s’est déroulée avant l’allogreffe pour quatre patients et après pour les six autres, qui étaient encore sous immunosuppresseurs au moment de la procédure.
Fer de lance de l'arsenal thérapeutique moderne, les antibiotiques ont sauvé des millions de vie. En revanche, leur utilisation excessive et parfois injustifiée peut conduire à l'apparition de différentes formes de résistance chez les micro-organismes. Chaque année, l'Organisation Mondiale de la Santé (OMS) organise la Semaine mondiale de sensibilisation à la résistance aux antimicrobiens (WAAW) afin de sensibiliser la population sur ce problème de santé publique. Lisez la page qui y est consacrée.
Résistance aux antibiotiques : le microbiote au premier plan
Une efficacité confirmée
Dans 7 cas sur 10, les médecins ont observé une décolonisation majeure des souches multi-résistantes (3 cultures bactériennes successives négatives). Chez 6 patients sur 10, cette décolonisation était persistante, c’est-à-dire observée tout au long du suivi (4-40 mois). Les trois échecs pourraient s’expliquer par des difficultés méthodologiques (impossibilité de stopper les antibiotiques 72h après la transplantation fécale, administration trop courte ou quantité trop faible de selles…). Enfin, lorsque la première transplantation n’a pas suffi à éliminer les bactéries multi-résistantes, une seconde transplantation s’est révélée à la fois possible et efficace dans 2 cas sur 3.
Qu’est ce que la Semaine mondiale de sensibilisation à la résistance aux antimicrobiens ?
Depuis 2015, l'OMS organise chaque année la Semaine mondiale de sensibilisation à la résistance aux antimicrobiens (WAAW) dont l'objectif est de sensibiliser sur le phénomène mondial de la résistance aux antimicrobiens. Cette campagne, qui se tiendra du 18 au 24 novembre, encourage le grand public, les professionnels de santé et les décideurs à faire un bon usage des antimicrobiens afin d'éviter l'apparition de résistance.
Une sûreté démontrée
Chez les 10 patients, la TMF s’est avérée sans risque majeur : un patient a présenté une constipation au cours des cinq premiers jours suivant la transplantation ; deux autres une diarrhée passagère et sans sévérité. Pour les chercheurs, aucun des 3 décès enregistrés n’est attribuable à la TMF : 2 concernent des patients dont la maladie a progressé ; le troisième un patient ayant reçu deux transplantations fécales en raison d’un (sidenote: GVHD Graft-versus-host disease, ou maladie du greffon contre l’hôte ) sévère déclaré post greffe de CSH et dont le traitement par immunosuppresseurs a favorisé la survenue d’une infection virale et fongique 6 mois après TMF. Ainsi, chez les patients infectés par des bactéries multi-résistantes, la TMF semble représenter une solution efficace et sans risque, même en cas d’immunodépression sévère.
Nous vous présentons le Professeur Sørensen, lauréat de la bourse internationale 2022 de la Biocodex Microbiota Foundation.
Son équipe a été la première à lancer une étude ambitieuse sur le résistome de 700 enfants, qui permettra de faire un pas de géant dans la compréhension de l'évolution et de la dissémination de la résistance aux antibiotiques dans l'intestin humain au cours de la petite enfance.
Expliquez ce qu'est la greffe fécale à vos patients grâce à ce contenu dédié: